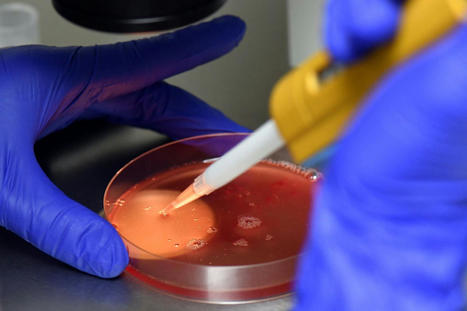
Le Comit&eacute; consultatif national d&rsquo;&eacute;thique alerte contre l&rsquo;eug&eacute;nisme | Bio&eacute;thique & Procr&eacute;ation | Scoop.it
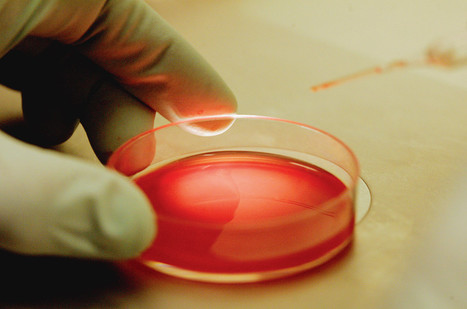
Pierre Le Coz&thinsp;: &laquo;&nbsp;&Agrave; quoi sert le CCNE s&rsquo;il suit l&rsquo;air du temps&thinsp;?&nbsp;&raquo; | Bio&eacute;thique & Procr&eacute;ation | Scoop.it

Your new post is loading...
 Your new post is loading...

|
Scooped by
Alliance VITA
April 3, 5:11 AM
|
Alors que la France affiche une natalité en baisse, un avis du Comité consultatif national d’éthique (CCNE) publié jeudi 3 avril plaide pour une meilleure information des Françaises et des Français sur les causes de l’infertilité mais aussi sur les limites de l’aide médicale à la procréation, trop souvent vue comme miraculeuse.

|
Scooped by
Alliance VITA
February 18, 2022 6:23 AM
|
Dans un avis publié mercredi 16 février, le CCNE alerte sur les dangers de l’eugénisme et appelle les chercheurs comme la société à la vigilance et à l’humilité.

|
Scooped by
Alliance VITA
February 1, 2022 3:38 AM
|
Depuis sa création, en 1983, par François Mitterrand, le Comité consultatif national d’éthique (CCNE) n’a, à mon sens, pas démérité. Les avis publiés sont réfléchis, représentatifs des grands enjeux de l’époque.

|
Scooped by
Alliance VITA
July 9, 2019 11:39 AM
|
Si Jean-François Delfraissy encourage l'ouverture à la PMA pour toutes, il reste fermement opposé à la gestation pour autrui. Le président du comité national d'éthique rappelle que, selon lui, cette pratique suppose la « marchandisation du corps de la femme ».

|
Scooped by
Alliance VITA
January 29, 2019 4:28 AM
|
À la tête du Comité national consultatif d’éthique (CCNE) depuis décembre 2016, le Pr Jean-François Delfraissy a été reconduit à la présidence pour une période de deux ans renouvelable, selon un décret paru mardi au « Journal officiel ».

|
Scooped by
Alliance VITA
September 28, 2018 4:45 AM
|
Dans une tribune au « Monde », le haut-fonctionnaire Jean-Christophe Parisot de Bayard estime que l’avis du Comité consultatif national d’éthique ne tient pas compte des droits de l’enfant et ouvre en grand la porte aux transhumanistes.

|
Scooped by
Alliance VITA
September 26, 2018 10:53 AM
|
Que pourrait-il se passer si le gouvernement suivait l’avis du Comité consultatif national d’éthique? Autant redouté qu’attendu, l’avis du Comité consultatif national d'éthique (CCNE) sur les questions de procréation, et notamment la fameuse ouverture de la PMA aux femmes seules

|
Scooped by
Alliance VITA
September 25, 2018 3:31 PM
|
FIGAROVOX/ENTRETIEN - Alors que le CCNE a donné ce mardi son feu vert pour l'extension de la PMA, Aude Mirkovic regrette que les experts n'aient pas tenu compte des débats tenus lors des états généraux de la bioéthique.

|
Scooped by
Alliance VITA
September 25, 2018 11:39 AM
|
Le Comité consultatif national d’éthique (CCNE) a rendu ce matin un avis très attendu dans le cadre de la révision des lois de bioéthique.

|
Scooped by
Alliance VITA
September 25, 2018 3:12 AM
|
« Le grand risque de ces États généraux de la bioéthique est qu’ils remettent en permanence tout sur le tapis », soulignait en avril auprès d’Aleteia Tugdual Derville, le délégué général d’Alliance VITA. « Par effet de cliquet, cela revient à avaliser sans cesse de nouvelles transgressions en cassant la digue qui avait été précédemment établie. Plus globalement, verser un sujet dans la bioéthique peut finir par porter atteinte à un principe moral intangible. La bioéthique risque de devenir l’art de dissoudre la morale dans le relativisme. »

|
Scooped by
Alliance VITA
June 5, 2018 9:06 AM
|
Le président du CCNE livre les premiers enseignements des états généraux de la bioéthique, dont le compte rendu est publié mardi.

|
Scooped by
Alliance VITA
June 2, 2018 3:10 PM
|
Il faudra, mardi 5 juin 2018, être à la Maison de la Chimie, à Paris. Objet : découvrir le « rapport de synthèse » des États Généraux de la Bioéthique qui, alors, sera présenté à la presse par des membres du Comité consultatif national d’éthique. Peu après des membres du « Comité Citoyen » présenteront les « Opinions » émises par ce dernier.

|
Scooped by
Alliance VITA
May 31, 2018 5:26 AM
|
Le philosophe Frédéric Worms, membre du Comité consultatif national d’éthique, explique l’exception française en matière de politique sur le vivant.
|

|
Scooped by
Alliance VITA
February 21, 2023 4:20 AM
|
Créée par un décret signé par le président Mitterrand, cette institution publique fête jeudi 23 février ses quarante ans d’existence. Son avis sur la fin de vie publié en septembre a relancé la polémique sur son utilité. Longtemps jugé conservateur, le CCNE serait-i

|
Scooped by
Alliance VITA
February 17, 2022 6:35 AM
|
Régulièrement employé lors des débats sur la nouvelle loi de bioéthique, le terme d'eugénisme fait l'objet d'un...

|
Scooped by
Alliance VITA
August 30, 2019 5:45 AM
|
Sur la PMA, « il n’y avait pas de consensus au niveau du CCNE », a rappelé mercredi 28 août son président Jean-François Delfraissy, auditionné par la Commission spéciale chargée d’examiner le projet de loi de bioéthique.

|
Scooped by
Alliance VITA
February 6, 2019 4:21 AM
|
La méthode de consultation mise en place pour organiser les Etats généraux de la bioéthique devrait servir d’exemple au grand débat national, estiment dans une tribune au « Monde » Jean-François Delfraissy, président du Comité consultatif national d’éthique pour les sciences de la vie et de la santé, et Pierre-Henri Duée, président de la section technique du CCNE.

|
Scooped by
Alliance VITA
October 4, 2018 5:02 AM
|
Le Docteur Xavier Mirabel réagit à l'avis rendu par le CCNE sur le futur projet de loi de bioéthique.

|
Scooped by
Alliance VITA
September 28, 2018 3:08 AM
|
Tugdual Derville, délégué général d'Alliance VITA, revient sur l'avis favorable du CCNE pour l'ouverture de la PMA aux femmes seules et aux couples de femmes.

|
Scooped by
Alliance VITA
September 26, 2018 5:42 AM
|
Pierre Le Coz, philosophe, ancien vice-président du Comité consultatif national d’éthique (CCNE) met en garde contre le triomphe de l’autonomie sur toute autre valeur.

|
Scooped by
Alliance VITA
September 25, 2018 12:31 PM
|
Tugdual Derville, délégué général d’Alliance VITA, était l’invité de Patrick Roger et Cécile de Ménibus, dans l’émission « Le Grand Matin » de Sud Radio, le 25 septembre 2018. Il réagit à l’avis favorable du CCNE rendu le jour-même à propos de l’ouverture de la PMA aux femmes seules et aux couples de femmes.

|
Scooped by
Alliance VITA
September 25, 2018 3:16 AM
|
Avant la révision de la loi de bioéthique, il propose aussi de rendre possible la levée de l'anonymat des futurs donneurs de sperme pour les enfants issus de ces dons et d'autoriser l'autoconservation des ovocytes pour les femmes qui veulent préserver leur fertilité.

|
Scooped by
Alliance VITA
June 14, 2018 2:34 AM
|
Le docteur Xavier Mirabel revient sur le rapport de synthèse des états généraux de la bioéthique.

|
Scooped by
Alliance VITA
June 4, 2018 4:00 AM
|
Le Comité consultatif national d’éthique remet au Parlement, lundi 4 juin, un rapport sur la bioéthique. Les catholiques ont été très présents dans les débats, note la sociologue des religions, avec des positions plus ouvertes que celles de La Manif pour tous.

|
Scooped by
Alliance VITA
June 1, 2018 5:50 AM
|
Le rapport de synthèse des États généraux de la bioéthique sera rendu public mardi 5 juin, a indiqué jeudi le Comité consultatif national d'éthique (CCNE), qui pilote cette consultation destinée à nourrir une nouvelle loi.
Le rapport sera remis à l'Office parlementaire d'évaluation des choix scientifiques et technologiques (OPECST), présidé par Gérard Longuet et coprésidé par le mathématicien Cédric Villani.
|
 Your new post is loading...
Your new post is loading...
 Your new post is loading...
Your new post is loading...